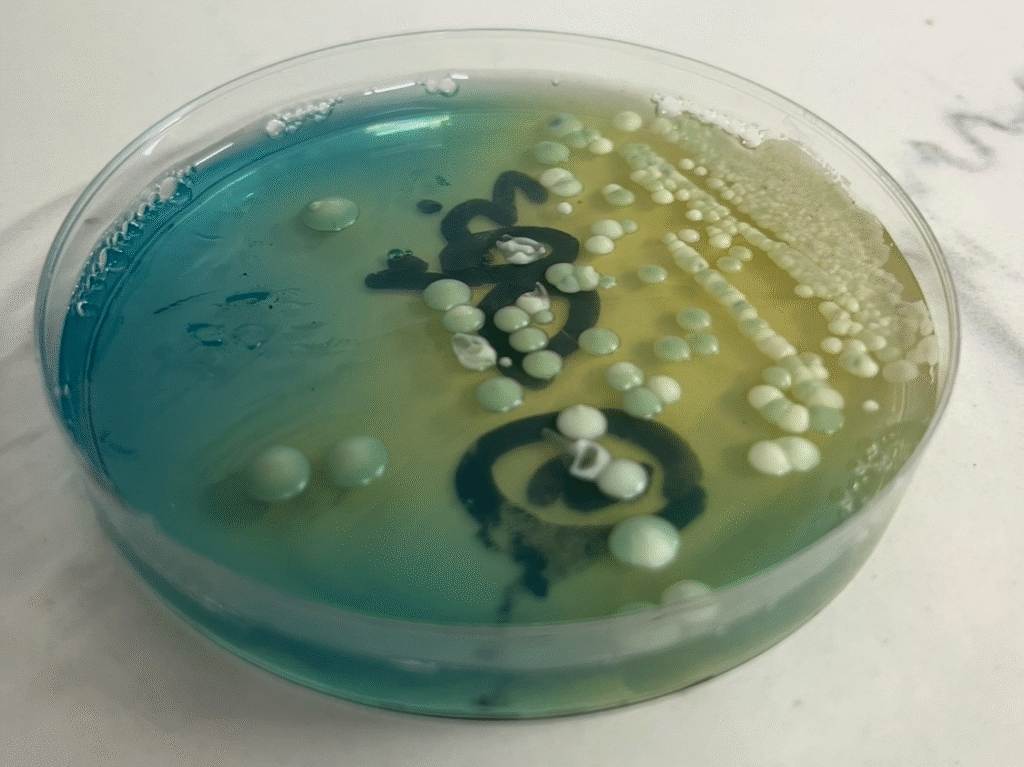

“La estandarización amenaza al vino argentino: por primera vez un proyecto científico busca rescatar su autenticidad”
- En un mercado global cada vez más competitivo, la diferenciación se ha convertido clave para las bodegas.
- La búsqueda de una identidad única, de un vino que hable del lugar donde nace, ha llevado a la industria a mirar más allá de las barricas y a sumergirse en un universo invisible a los ojos, pero de un poder transformador: el de las levaduras nativas.

Buenos Aires, diciembre de 2025. – El sector vitivinícola de Argentina enfrenta una encrucijada. Por un lado, goza de un merecido prestigio internacional, con el Malbec argentino, consolidado en todo el mundo. Por otro, se enfrenta a desafíos significativos como la caída del consumo interno, una fuerte carga impositiva y la necesidad de conquistar el mercado actual, tanto interno como de exportación. En este escenario, la homogeneización de los sabores representa una amenaza latente. Durante décadas, la industria ha confiado en un puñado de levaduras comerciales seleccionadas por su eficiencia y previsibilidad. Estas cepas, verdaderas “obreras” de la fermentación, cumplen su trabajo de manera impecable, pero a un costo: la estandarización del perfil sensorial de los vinos.
En un momento sediento de autenticidad, donde el consumidor busca historias y experiencias en lo que consume y toma, esta uniformidad se convierte en un obstáculo para el crecimiento y la diferenciación.
Es en este contexto que surge un ambicioso proyecto de investigación científica, liderado por el microbiólogo argentino Germán Gonzalez Riachi y creador de Ciencia del Vino, un proyecto que busca transformar la elaboración de vinos, promoviendo mayor identidad, sustentabilidad y autonomía para cada productor. La iniciativa propone llevar adelante por primera vez en el país un estudio a escala nacional para mapear la diversidad microbiológica del país y su impacto en el terroir vitivinícola. El corazón de este proyecto es un laboratorio móvil de última generación, diseñado para recorrer las principales regiones productoras de la Argentina y trabajar en colaboración directa con las bodegas.
La metodología del estudio se centra en una premisa fundamental: en lugar de depender completamente de levaduras genéricas, la investigación busca aislar, identificar y caracterizar los microorganismos que ya existen de forma natural en cada viñedo y bodega. Estos microorganismos, conocidos como levaduras nativas, son, en esencia, la “firma” microbiológica del terroir.
Pero, ¿qué son exactamente las levaduras nativas? Son microorganismos autóctonos de una región, viñedo o bodega, capaces de fermentar y producir vino. A diferencia de las levaduras comerciales, que son seleccionadas y producidas para ser utilizadas en cualquier parte del mundo, las levaduras nativas son únicas de cada lugar. “Las levaduras nativas son el resultado de un fascinante proceso de selección natural. Cada viñedo y bodega alberga su propia comunidad microbiana única, una suerte de “huella digital” invisible moldeada por factores como el clima, la composición del suelo, las variedades de uva cultivadas, las prácticas agrícolas, los métodos de vinificación y la propia historia del lugar”, comenta German.
En el caso específico del vino, esta comunidad microbiana se ve influenciada por la presencia de alcohol, un pH bajo y la alta concentración de azúcar del mosto, condiciones extremas que solo los microorganismos mejor adaptados logran superar. Las levaduras nativas son, en este sentido, la “firma” microbiológica del terroir.
“La diferencia fundamental con las levaduras comerciales radica en la identidad que confieren al vino. Mientras que la mayoría de las bodegas fermentan cepas similares genéricas, lo que inevitablemente conduce a una cierta similitud en los perfiles aromáticos y gustativos, las levaduras nativas aportan características sensoriales distintivas y particulares a cada vino. Son ellas las que permiten que un vino de una región se diferencia de otro, no solo por el clima o el suelo, sino también por su microbiología”, explica German.
“Existe un riesgo cuando fermentamos de manera espontánea con levaduras nativas ya conocidas por los bodegueros, por ello muchas veces para lograr seguridad los enólogos optan por la siembra de levaduras” alerta Germán y agrega: “lo novedoso es que ahora los productores tienen la posibilidad de sembrar con sus propias levaduras seleccionadas, obteniendo seguridad fermentativa por inocular una buena cantidad de levaduras .pero también logrando un perfil sensorial único ya que la levadura que fermentó es una levadura única de ese terroir”.
El laboratorio móvil, núcleo de esta investigación de campo, aplicará un protocolo para el muestreo y selección de levaduras nativas directamente en cada bodega participante. De esta manera, los productores podrán descubrir y utilizar cepas propias de alto desempeño, adaptadas a su entorno y a su estilo de vinificación, logrando un carácter único del vino.

Un equipo de microbiólogos tomará muestras de las uvas, del suelo, de las instalaciones y del ambiente de la bodega para construir un perfil microbiológico completo del terroir. En el laboratorio, se aplicarán protocolos de caracterización y selección, sometiendo la cepa a condiciones de estrés propios de la fermentación y evaluación de capacidades fermentativas de la levadura nativa seleccionada. Posteriormente, se realizarán microvinificaciones para evaluar el comportamiento fermentativo de las cepas nativas en bodega, su resistencia al alcohol, su perfil de producción de aromas y su impacto sensorial general. Las cepas con mayor potencial enológico serán seleccionadas y criopreservadas, creando un valioso banco de levaduras para la bodega.
“Este enfoque ofrece una serie de ventajas competitivas para las bodegas. En primer lugar, les permite diferenciarse de la competencia, ofreciendo vinos con una identidad única e irrepetible. En segundo lugar, les brinda un mayor control sobre el proceso de fermentación, ya que la levadura nativa se siembra igual que las levaduras comerciales. Y en tercer lugar, les permite agregar valor a sus vinos, al poder comunicar al consumidor la historia detrás de su terroir, una historia que ahora incluye a sus propios microorganismos”, agrega German.
La participación en este estudio representa una oportunidad para que las bodegas no solo accedan a tecnología de punta, sino que también se conviertan en colaboradoras activas de una investigación que busca profundizar el conocimiento del terroir argentino. Es una invitación a ser pioneros en la exploración de nuevas fronteras sensoriales y en la creación de vinos que expresen, con una fidelidad sin precedentes, la identidad de su origen.
El proyecto invita a las bodegas a sumarse como centros de investigación asociados y explorar el universo de sus levaduras nativas y contribuir a este mapeo nacional del microbioma vitivinícola. Esta colaboración no solo ofrece la posibilidad de desarrollar vinos con una personalidad única, sino que también representa una oportunidad para fortalecer la marca a través de la innovación y el conocimiento científico. El futuro del vino, y su más profunda expresión, reside en el estudio de sus raíces microbiológicas.
FUENTE: CIENCIA DEL VINO




